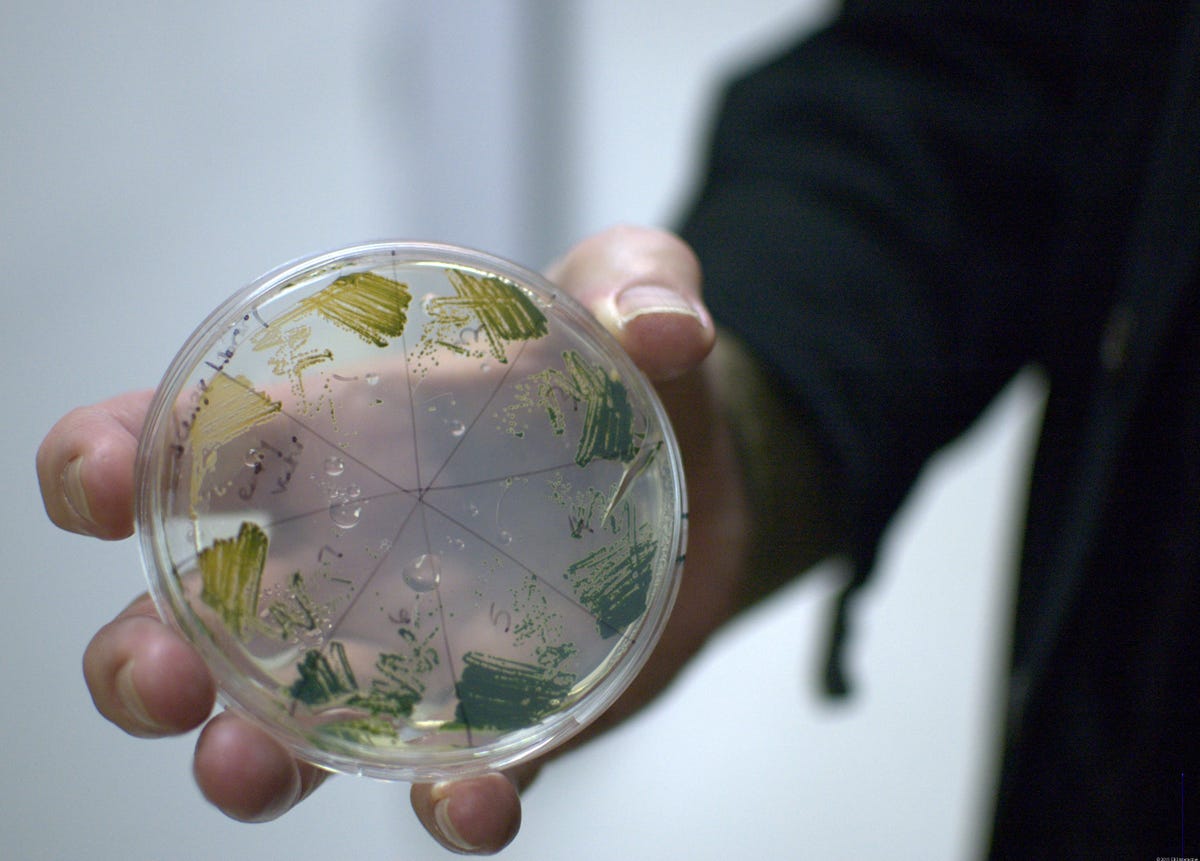
petri.jpg

Growing colonies
CAMBRIDGE, Mass.--Joule Unlimited is one of many companies using gene databases and genetic engineering to design a better system for making biofuels. Here the senior vice president of biological services, Dan Robertson, shows off a petri dish where employees grow different strains of a cyanobacteria Joule Unlimited has engineered to make diesel fuel.
Demo plant
Designing a microbe is only half of Joule's work. The other is making bioreactors, such as this one now being tested at a facility in Texas. The cyanobacteria are designed to secrete a fuel, which naturally separates from the solution it grows in and is extracted from the top of the bioreactor. Water and carbon dioxide from a power plant or wastewater facility is pumped in from the bottom and circulated through the other bioreactors. Scaling up should be straightforward because it simply means building more of the same types of reactors.
Gene therapy
Growing a colony of a particular strain can take about a day, but molecular biologists are trying hundreds of different gene combinations. About 80 percent of a biologist's time is spent on the computer, identifying genes and designing lab tests.
Tweaking conditions
As part of its testing, Joule Unlimited purchased specialized equipment that allows biologists to get fine-grained control over the environmental conditions for growing microbes. Here carbon dioxide and nitrogen, the main element in air, is pumped in from the bottom to stimulate growth of the cyanobacteria. Red LEDs (seen a bit at bottom of photo) are the source for mimicking sunlight.
Metabolic engineering
With these machines, biologists can mimic the light that they can anticipate in different regions over the course of the day or during different seasons. They can also test how factors such as pH and oxygen levels can affect growth rates.
Incubator
An incubator for growing sample strains allows biologists to control different environmental factors and measure growth rates.
Metabolic engineering
Joule Unlimited is focused on metabolic engineering, or manipulating the functions of organisms, in this case to make fuel. This poster appears in a few spots at the company's lab. An organism has a number of biological pathways to perform certain functions, such as regulating metabolism for changing environmental conditions or multiplying. Through its engineering, Joule Unlimited is controlling those metabolic pathways so that organisms will secrete hydrocarbon molecules which can be used for liquid fuel or other chemicals.
Biotech avenue
Joule Unlimited is located in Kendall Square, Cambridge, among a stretch of older buildings dubbed "Life Sciences Square" in the neighborhood of many pharmaceutical companies. Having an infrastructure, such as third-party companies to do DNA sequencing, around genetic engineering helps the company rapidly identify promising strains.

